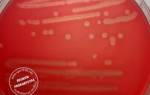

В статье про кокковую флору мы рассказали о различных микроорганизмах, которые тем или иным образом могут навредить женским репродуктивным органам. Большинство живущих во влагалище кокков — условно-патогенные, обычные представители флоры.
Но иногда их наличие крайне нежелательно. Так, в конце беременности большую опасность представляют стрептококки группы B (Strept.
Agalactiae) или стрептококк агалактия — это грамположительный микроорганизм — возбудитель смертельно опасных заболеваний.
Бактерии живут во влагалище и кишечнике у каждой 3-4 женщины. И это не венерическая болезнь. Однако данные микроорганизмы, как и любые другие, могут передаваться от одного полового партнера к другому. В большинстве случаев бета-гемолитический стрептококк не вызывает болезни. Но у некоторых людей могут провоцировать тяжелые инфекции или Б-стрептококковую болезнь (БСБ).
К содержанию
Streptococcus agalactiae провоцирует:
- инфекцию мочевыделительной системы;
- послеродовые осложнения;
- пневмонию;
- неонатальный сепсис;
- эндокардит;
- менингит;
- артрит.
В группу риска входят новорожденные дети, особенно недоношенные, а также взрослые люди с хроническими заболеваниями и низким иммунитетом, пожилые.
В США проводили подсчет новорожденных, у которых за определенный промежуток времени был диагностирован стрептококковый менингит. Это около 8000 детей. И 800 из них умирает. А у каждого пятого из оставшихся в живых бывают осложнения: потеря зрения, слуха, умственная отсталость и паралич.
Как заражаются новорожденные? Обычно это происходит во время естественных родов, кесарева сечения или преждевременном разрыве плодных оболочек — даже если это так называемый верхний боковой надрыв, когда воды только немного подтекают. Инфекция таким образом попадает в воды, которые заглатывает малыш.
К содержанию
Когда женщина просто носитель бактерии со здоровой, палочковой микрофлорой влагалища и не высокими лейкоцитами, никаких признаков инфекции у нее нет. Если же количество стрептококка group b растет, то появляются следующие симптомы:
- зуд и жжение в области половых губ и влагалища;
- необычные выделения, чаще желтые.
Если женщина в период появления данной симптоматики сдает мазок на флору, то в нем определяется множество кокков и увеличенное число лейкоцитов. Тогда врач сразу назначает лечение либо направляет анализ женщины на бакпосев для диагностики конкретного возбудителя заболевания и определения его чувствительности к тому или иному антибактериальному средству.
В норме streptococcus agalactiae либо отсутствует в микрофлоре влагалища и цервикального канала, либо находится там в небольшом количестве — 10 в 3 или 10 в 4 степени. Если же его наличие подсчитано как 10 в 5, 6, 7 степени и более — требуется лечение.
К содержанию
Мы рассмотрим 4 ситуации.
Лечение проводится непосредственно перед родами или даже в родах или после отхождения околоплодных вод. Но не менее, чем за 4 часа до появления ребенка на свет.
Беременной вводят внутримышечно или внутривенно антибиотики пенициллиновой группы, макролиды или цефалоспорины.
Колоть антибиотики за несколько недель до родов не имеет особого смысла, так как стрептококк вновь заселит влагалище вскоре после окончания терапии.
4. Кормящая мать. При наличии признаков недуга во время лактации, рекомендуют лечение без антибиотиков — препаратами местного действия. Достаточно свечей «Гексикон» (хлоргексидин) по одному и два суппозитория в день в течение одной недели. Затем любой вагинальный препарат, содержащий лактобактерии.
Чтобы не быть голословными, мы изучили различные отзывы женщин об избавлении от потенциально опасных стрептококков gr.b. И вот такие методы лечения мы нашли.
| Вариант антибактериального местного лечения | Метромикон-нео по 1 суппозиторию утром и на ночь в течение 7 дней подряд. |
| Комплексная схема для 1-2 триместра беременности | Амоксиклав по 1 таб. 375 мг каждые 8 ч + свечи «Гексикон» вагинально 7 дней по 1 на ночь. |
| Комбинированное лечение | Азитромицин 1 г однократно;Ветадин по 1 св. №10;Трихопол по 1 таб. 3 р/день №7;Дифлюкан однократно. |
| Санация влагалища антисептиком | Свечи Флуамизин — 1 вагинальная таб./сут (6 дней). |
Также для лечения используются следующие антибиотики:
- Бензилпенициллин (Benzylpenicillin);
- Ванкомицин (Vancomycin);
- Доксициклин (Doxycycline);
- Левофлоксацин (Levofloxacin);
- Линезолид (Linezolid);
- Фосфомицин (Fosfomycin);
- Цефтриаксон (Ceftriaxone).
Системный (внутрь) прием антибиотика обязательно нужен при обнаружении бактерии в моче у беременной.
К содержанию
Источник: https://viskablivanie.ru/streptokokk-agalaktiya-v-mazke-u-zhenshin.html
Рассказать ВКонтакте в Одноклассниках в
Часть микрофлоры организма составляют условно-патогенные бактерия, такие как стрептококки группы В рода агалактия.
В норме они присутствуют в теле человека в низких концентрациях, не оказывая влияния на работу его органов и систем.
Воспаление начинается при их интенсивном размножении, под воздействием внешних или внутренних провоцирующих факторов (изменения гормонального фона, падение иммунитета).
Группа условно-патогенных бактерий, называемая стрептококками, в небольших концентрациях может присутствовать в организме человека, не вызывая развития инфекции или воспаления.
Все микроорганизмы рода Streptococcus по характеру роста на питательных средах подразделяют на гемолитические, негемолитические и зеленящие.
Стрептококки из рода агалактия (Streptococcus agalactiae) относятся к грамположительным бета-гемолитическим стрептококкам группы В.
Показателями нормы считают концентрации не более 10 в 4 степени КОЕ/мл.
Инфекции, вызываемые стрептококками этого типа при росте их концентраций, особенно опасны для новорожденных и людей пожилого возраста, для которых они чреваты уросепсисом, перитонитом и пневмонией, инфекциями костей и кожи.
К основным путям попадания бактерии рода агалактия в организм относят половой, бытовой, воздушно-капельный, пищевой, и пренатальный или интранатальный (от матери к новорожденному). Активное размножение стрептококков происходит на фоне нарушения баланса нормальной микрофлоры из-за ряда следующих факторов:
- ослабление иммунитета;
- нарушение правил интимной личной гигиены;
- регулярные спринцевания (у женщин);
- гормональные сбои;
- ношение нижнего белья из синтетических тканей;
- незащищенный сексуальный контакт.
Стрептококк агалактия у мужчин активизируется либо после секса без использования презерватива, либо на фоне дисбактериоза кишечника после антибиотикотерапии или в следствие влияния иных факторов. После первоначального инфицирования носитель становится способен передавать бактерию возбудителя своим половым партнерам (самый распространенный путь передачи инфекции).
Отдельную группу риска представляют собой новорожденные. По статистике, носителями стрептококка Agalactiae является около 30% всех здоровых женщин, у которых во время беременности на фоне гормональных изменений могут обостряться вызываемые патогенным микроорганизмом инфекции (циститы, уретриты и др.). Угроза заражения ребенка растет при следующих обстоятельствах:
- возраст матери старше 20 лет;
- аборты или выкидыши в медицинском анамнезе матери;
- преждевременные роды (до 37 недели);
- амнионит;
- хроническая инфекция мочеполовых путей;
- задержка внутриутробного развития;
- лихорадочный синдром во время родов.
Микроорганизмы типа агалактия при интенсивном размножении вызывают инфекционные заболевания мочеполовой системы, сопровождающиеся воспалительным процессом. Активность бактерии сопровождается выделением следующих соединений и токсичных веществ:
- Некротоксинов и летальных токсинов, провоцирующих некроз тканей.
- Лейкоцидина, разрушающего клеточный иммунитет.
- Стрептолизина, способствующего разрушению тканей.
- Амилаза, гиалуронидаза, протеиназа, способствующие распространению стрептококковой инфекции.
Бактерия стрептококк агалактия в моче или влагалищном мазке в увеличенных концентрациях свидетельствует о текущем воспалительном инфекционном процессе. В зависимости от типа инфекции, проявляется характерная симптоматика:
- При инфицировании мочевыделительных путей – зуд или жжение в области половых органов, цервикального канала, учащенные болезненные мочеиспускания, отечность и покраснение половых губ или анальных складок, боли в нижней части живота, выделения из мочеиспускательного канала.
- При стрептококковом тонзиллите (ангине), фарингите и др. бактериальных инфекциях дыхательных путей – лихорадка, признаки тяжелой общей интоксикации, поражение слизистых.
Согласно статистике, стрептококки в мазке у женщин почти в 40% случаев обнаруживаются во время беременности. На фоне сниженного иммунитета максимально активное размножение агалактии наблюдается на 33-37 неделе, поэтому на этих сроках обязательно назначаются анализы для выявления возбудителя и его обезвреживания (при необходимости). Факторами, увеличивающими риск инфицирования, являются:
- обнаружения стрептококков этой группы в моче;
- диагностированная угроза преждевременных родов;
- диагностирование стрептококковой инфекции у предыдущих детей.
У беременной женщины агалактии могут вызывать воспаления мочеполовой системы, легких, спровоцировать следующие опасные осложнения беременности и родовой деятельности:
- эндометрит (воспаление внутренней оболочки матки);
- преждевременное отхождение околоплодных вод;
- хориоамнионит (воспаление плодных оболочек);
- выкидыш на любом сроке;
- преждевременное родоразрешение;
- сепсис, менингит, эндокардит(воспаление внутренней оболочки сердца) у новорожденного.
Обнаруживается стрептококк агалактия в мазке из влагалища, уретры или прямой кишки, который может быть назначен при обнаружении кокковой флоры в анализе мочи.
После обследования биоматериала методом лабораторной микроскопии проводят посев на питательную среду, помогающий точно идентифицировать тип бактериального заражения, степень концентрации микроорганизмов и их устойчивость к антибактериальным препаратам.
Дополнительно назначаемыми анализами являются скрининг-тесты: ИФА (иммуноферментный анализ) и метод ПЦР (полимеразно-цепной реакции). Остальные лабораторные и инструментальные методы диагностики (общий и биохимический анализ крови, мочи, УЗИ и пр.) назначаются для выявления заболеваний, развитие которых вызвано активным размножением Streptococcus agalactiae.
Необходимость медикаментозного лечения возникает при обнаружении концентраций стрептококков этой группы до 10 в четвертой степени КОЕ/мл и выше, даже если инфекция протекает скрыто.
При воспалении мочеполовых органов терапию проходят оба половых партнера, при инфекции смешанного типа возможен прием антибиотиков разных фармакологических групп, при хронической форме заболевания пациенту с острой стадией болезни рекомендован прием иммуностимуляторов, ферментов, прохождение курса физиотерапии.
В зависимости от типа инфекции антибактериальные препараты назначаются в форме средств для перорально приема или в иных лекарственных формах (например, вагинальные таблетки или свечи Флуомизин, Тержинан, Гексикон,). Активность по отношению к агалактии проявляют пенициллины (Оксациллин, аминопенициллины), макролиды (Эритромицин) и Цефалоспорины (Цефазолин).
Если существует опасность заражения ребенка во время родов, матери назначаются внутривенные инъекции, проводимые прямо при родоразрешении, может рекомендоваться антибактериальная санация родовых путей перед родами. После курса антибиотиков и выведения бактерии требуется терапия с применение пробиотиков или энтеросорбентов (например, Атоксила) для восстановления естественной нормальной микрофлоры кишечника.
К профилактическим мерам предотвращения стрептококкового заражение является соблюдение правил личной гигиены и безопасности половых контактов, мероприятия по поддержанию естественного иммунитета, нормального баланса микрофлоры:
- полноценное питание;
- активный образ жизни, занятия спортом;
- здоровый режим дня;
- прием витаминов;
- закаливание организма, избегание переохлаждения;
- полноценный отдых;
- отказ от вредных привычек.
35 неделя беременности что происходит с малышом и мамой, стрептококк, готовимся в роддом
Внимание! Информация, представленная в статье, носит ознакомительный характер. Материалы статьи не призывают к самостоятельному лечению. Только квалифицированный врач может поставить диагноз и дать рекомендации по лечению, исходя из индивидуальных особенностей конкретного пациента.
Нашли в тексте ошибку? Выделите её, нажмите Ctrl + Enter и мы всё исправим!
Источник:
Стрептококк агалактия оседает преимущественно в мочеполовой системе и кишечнике, приводит к развитию инфекционных заболеваний у молодых матерей и младенцев. Рассматриваемая стрептококковая инфекция относится к микрофлоре условно-патогенного характера, возбудителем которой является бета-гемолитический стрептококк.
Стрептококк агалактия – единственный представитель стрептококков группы В
Streptococcus agalactiae – единственный вид стрептококков, который относится к группе В. Выявление этой бактерии в мазке, взятом из цервикального канала, свидетельствует о наличии неспецифического воспалительного процесса.
Во время проведения микроскопических исследований микроб окрашивается по Грамму. Если после промывания он не теряет цвета, то инфекцию относят к грамположительным бактериям.
Стрептококк под микроскопом
Источник: https://dikulug.ru/infektsii/streptococcus-agalactiae-streptokokk-agalaktiya-chto-eto-norma-svojstva-lechenie.html
Микрофлора влагалища включает разнообразные микроорганизмы, в том числе патологические. Они не влияют на состояние здоровой женщины, но могут активизироваться в условиях сниженного иммунитета.
Состав микрофлоры определяет состояние нормы и патологии. Когда в мазке из цервикального канала выявляют большое количество условно-патогенной флоры, это указывает на развитие воспалительного процесса.
К такой флоре относят стрептококк агалактия.
Большая часть от нормальной флоры влагалища – палочки лактобактерий. К условно-патогенной флоре относят стрептококки, стафилококки, кандиды, гарднереллы, уреаплазмы и микоплазмы. Если количество этих микроорганизмов не превышает норму, состояние влагалища будет удовлетворительным.
Одним из возбудителей неспецифического воспаления выступает стрептококк агалактия. Группа стрептококков включает большое количество разных микроорганизмов схожих по морфологическим признакам. По типу роста на питательной среде различают гемолитические, негемолитические и зеленящие микроорганизмы.
В среде влагалища встречаются стрептококки групп В и D, а также зеленящие. Агалактия – бета-гемолитический стрептококк из группы В. Норма стрептококков составляет 10 в 4 степени КОЕ/мл.
Заселение стрептококков в среду влагалища происходит в пубертатный период, особенно в начале половой жизни. Возможно и самозаражение из анальных складок, если во время подмывания направлять движения от анального отверстия.
Группы риска:
- женщины, которые перенесли преждевременные роды;
- повышение температуры во время родов;
- безводный промежуток более 18 часов;
- рождение недоношенного ребенка;
- младенцы с недостаточным весом;
- кесарево сечение;
- наличие бактерий в моче.
Во время родов женщина может инфицировать новорожденного. Стрептококки передаются также бытовым путем через предметы гигиены общего пользования. Мужчина может инфицироваться во время орального или анального контакта.
Пока стрептококков в среде влагалища мало, преобладают лактобактерии. В большом количестве они могут подавлять рост условно-патогенной флоры и защищать от воспаления. Стрептококк активизируется при дисбалансе микрофлоры влагалища.
Причины нарушения баланса микрофлоры:
- гормональные изменения;
- ослабление иммунитета;
- несоблюдение правил личной гигиены;
- спринцевание;
- тяжелые системные патологии (сахарный диабет).
Во время беременности воспаление развивается сразу из-за двух факторов (иммунитет и гормоны). Повышение уровня прогестерона негативно сказывается на местном иммунитете, что необходимо для сохранения беременности. Однако на этом фоне нередко обостряются латентные инфекции мочеполовой системы.
Мужчина инфицируются во время незащищенного полового акта. Он становится носителем и передает стрептококк своим половым партнерам.
Агалактия не дает выраженную симптоматику, отсутствует воспалительная реакция во влагалище. Возбудитель начинает действовать в уретре, поднимаясь выше по мочеполовым органам.
Возникают симптомы цистита: боль и жжение в процессе мочеиспускания, частые позывы с выделением небольшого объема мочи, чувство неполного опорожнения.
При остром цистите также ухудшается общее состояние, больной чувствует слабость и головные боли.
Схему лечения стрептококка агалактия выбираются в зависимости от состояния пациентки. Если болезнь протекает латентно, а женщина не планирует детей, можно ограничиться местной терапией. Когда пациента планирует беременность, лечение стрептококка начинают только после проявления симптоматики.
Беременные, у которых нет выраженных симптомов, должны наблюдаться у врача и пройти повторное обследование на 35 неделе. Во время лактации назначают местное лечение до исчезновения симптомов. Пероральные антибиотики не назначают, поскольку они попадают в грудное молоко.
Тактика лечения:
- Женщина планирует беременность. Терапию назначают только при вагинальном дискомфорте. Если выраженных симптомов инфекции нет, зачатие и вынашивание не запрещаются.
- Женщина не планирует беременность и имеет симптомы. Если посев мочи не содержит возбудители, назначают местное лечение для устранения симптоматики.
- Беременная с выявленным стрептококком в мазке или бакпосеве. Если стрептококк обнаружили на раннем сроке и нет признаков воспаления, назначают повторное обследование на 34-35 неделе. Терапию проводят перед родами или в родах (не менее, чем за 4 часа до родоразрешения). Женщине вводят антибиотики пенициллинового ряда, цефалоспорины или макролиды.
Проводить терапию за несколько недель до родов нецелесообразно: стрептококк заселит слизистую влагалища после окончания лечения.
- Период лактации. Во время кормления лечение антибиотиками может быть опасно для ребенка, поэтому отдают предпочтение местному воздействию. Обычно используют свечи Гексикон с хлоргексидином по 1-2 в день на протяжении недели.
После какой-нибудь вагинальный препарат с лактобактериями, чтобы восстановить микрофлору.
Обычно лечение начинают с Нитрофурантоина, который отличается универсальным действием. Если имеются стрептококки группы В, назначают Ампициллин, так как он накапливается в слизистой влагалища. Это позволяет осуществить профилактику заражения новорожденного.
Терапию стрептококка проводят с применением антибиотиков пенициллинового ряда при выявлении концентрации 10 в 5 степени КОЕ/мл. Остановить размножение микроорганизмов помогают также цефалоспорины и макролиды. Наиболее эффективными являются пероральные препараты.
Для лечения стрептококка можно применять антибиотики Доксициклин, Левофлоксацин, Ванкомицин, Цефтриаксон, Бензилпенициллин, Фосфомицин, Линезолид. Самолечение не рекомендовано, поскольку неправильный прием антибиотиков чреват формированием устойчивости и дисбалансом микрофлоры кишечника.
У беременных до 12 недели терапию не проводят, это обусловлено особенностями формирования плаценты (при титре 10 в 6 степени КОЕ/мл). С 4 месяца назначают пероральные препараты. Антибиотики внутрь обязательно назначают при выявлении стрептококка в моче у беременной. Самолечение при цистите у беременных может быть опасно. Некоторые антибиотики повышают риск перинатальной смерти.
Препараты:
- Антибактериальное местное лечение: Метромикон-нео (1 суппозиторий утром или перед сном на протяжении недели).
- Комплексное лечение для 1-2 триместра: Амоксиклав (375 мг каждые 8 часов, свечи), Гексикон (по 1 суппозиторию на ночь 7 дней).
- Комбинированная терапия: Азитромицин (1 г однократно), Дифлюкан (однократно), Ветадин №10, Трихопол (по 1 таблетке трижды в день).
- Санация влагалища: Флуомизин (1 вагинальная таблетка в сутки на протяжении 6 дней).
Важную роль играет профилактика осложнений. Если у одного из партнеров выявили стрептококковую инфекцию, второму рекомендуется сдать мазок (женщинам из влагалища, мужчинам из носоглотки).
Местная терапия включает вагинальные таблетки и свечи. Перед родами обязательно проводят санацию влагалища, чтобы уменьшить шансы на инфицирование ребенка. Если концентрация стрептококка превышает 10 в 8 степени и санацию не проводили, требуется антибактериальная терапия в родах. Санация родовых путей и антибиотики помогают снизить вероятность инфицирования ребенка до 1-2%.
Рекомендованные препараты:
- Флуомизин. Вагинальные таблетки, эффективные при бактериальном вагинозе. Таблетку нужно вводить во влагалище перед сном (6 дней). Микроорганизмы редко развивают устойчивость к средству, но использование препарата меньше 6 дней приводит к его неэффективности в следующий раз.
Противопоказания к Флуомизину: аллергия на компоненты, язвы слизистой влагалища, возраст до 18 лет.
- Тержинан. Препарат используют в терапии бактериальных и грибковых инфекций. Благодаря преднизолону в составе, Тержинан имеет противовоспалительные свойства и уменьшает отечность слизистой.
Беременные могут использовать Тержинан со второго триместра, в период лактации только с разрешения врача. Перед применением таблетку увлажняют. Во время менструации терапию не прекращают. Курс лечения составляет 10 дней.
- Гексикон. Свечи содержат хлоргексидин биглюконат, благодаря чему оказывают противомикробное и антисептическое воздействие. Гексикон эффективен при вагинозе и кольпите.
Можно использовать в период вынашивания и кормления ребенка. Для лечения стрептококка используют по 1 свече 1-2 раза в сутки на протяжении 7-10 дней (беременным 5-10 дней).
Во время беременности заподозрить стрептококк агалактия можно по частым уретритам и циститам, однако сдать анализ рекомендуется даже здоровым женщинам.
Дело в том, что агалактию выявляют у 20% беременных. Если у пациентки рождался инфицированный ребенок, обследование в последующих родах обязательно.
У женщины инфекция распространяется скрыто, но у младенца стрептококк может стать причиной осложнений.
Осложнения стрептококка у матери и ребенка:
- инфекции мочеполовых путей;
- послеродовой эндометрит (воспаление в поверхностном слое эндометрия матки);
- хориоамнионит (воспаление оболочек плода);
- самопроизвольный аборт;
- пневмония младенца;
- сепсис неонатального периода;
- эндокардит (воспаление внутренних оболочек сердца);
- менингит (воспаление оболочек мозга).
При лечении стрептококка агалактия отдают предпочтение комплексной терапии пенициллинами или цефалоспоринами. Отдельные препараты выбирают в зависимости от конкретной ситуации. Своевременное обращение к врачу поможет избежать осложнений не только у самой женщины, но также у ее ребенка.
- Гонал 33%, 35073507 33%3507 — 33% из всех
- Клостилбегит 25%, 2623 голоса2623 голоса 25%2623 голоса — 25% из всех
- Менопур 16%, 1704 голоса1704 голоса 16%1704 голоса — 16% из всех
- Пурегон 14%, 1523 голоса1523 голоса 14%1523 голоса — 14% из всех
- Прегнил 9%, 910910 9%910 — 9% из всех
- Меногон 3%, 323 голоса323 голоса 3%323 голоса — 3% из всех
Источник: https://BornInVitro.ru/infekcii-i-bolezni/agalaktiya/
Микрофлора влагалища представлена разнообразными микроорганизмами. В зависимости от их соотношения различают понятие нормы и патологии. Основу нормальной флоры составляют палочки – лактобактерии. Их дополняют условно-патогенные микроорганизмы, представленные стрептококками, стафилококками, гарднереллами, кандидами, уреа- и микоплазмами.
До тех пор, пока количество этих микроорганизмов незначительно, нет большого числа лейкоцитов, состояние влагалища считают удовлетворительным. Если в мазке из цервикального канала преобладает один из них, например, стрептококк агалактия, тогда диагностируют неспецифическое воспаление.
Стрептококки представляют собой большую группу микроорганизмов, сходных по морфологическим признакам. В зависимости от характера роста на питательных средах, серогруппы разделяют на гемолитические, зеленящие и негемолитические. Во влагалище присутствуют группы B, D и зеленящие. Показатели нормы не должны превышать 10 в 4 степени КОЕ/мл.
Агалактия относится к бэта-гемолитическим стрептококкам группы В. Это значит, что при посеве на питательную среду на основе агара и крови, по мере роста колонии вокруг нее образуется зона полного гемолиза эритроцитов. При этом питательная смесь обесцвечивается.
https://youtube.com/watch?v=1xwgCn0e7Zo
Активность микроорганизма сопровождается выделением различных токсических веществ:
- стрептолизин разрушает окружающие ткани;
- лейкоцидин разрушает клетки иммунитета, позволяет уходить от него микробам;
- некротоксин и летальный токсин вызывают некроз тканей;
- набор ферментов, которые помогают стрептококку внедряться в окружающие ткани: гиалуронидаза, протеиназа, амилаза, стептокиназа.
Заселение стрептококков происходит с периодом полового созревания и началом половой жизни. Возможен бытовой путь передачи при использовании общих предметов гигиены.
Женщины способны самозаражать себя, если при подмывании половых органов движения направлены сзади наперед. Микробы из анальных складок попадают во влагалище.
Беременная женщина во время родов способна инфицировать своего ребенка.
Мужчины могут заражаться от женщин во время орального или анального секса, через стенки кишечника при дисбактериозе, нисходящим путем из почек или носоглотки.
До того момента, пока количество возбудителя находится на минимальном уровне, во влагалище достаточно лактобактерий, которые подавляют рост условно-патогенной флоры. У мужчин стрептококк агалактия появляется после незащищенного полового акта. В дальнейшем они становятся носителями инфекции и способны предавать возбудителя другим партнершам.
Активация стрептококка происходит при нарушении баланса нормальной микрофлоры. К этому приводят следующие причины:
- изменение гормонального фона;
- снижение иммунитета;
- нарушение гигиенических процедур;
- использование спринцевания для личной гигиены;
- сахарный диабет и тяжелые патологии.
В период беременности первые два фактора особенно актуальны. Прогестерон, который постепенно повышается, угнетает местный иммунитет. Этот процесс направлен на сохранение беременности, но он имеет негативные последствия: у беременных часто обостряются скрытые инфекции мочеполовых органов, развиваются вагиниты и кольпиты.
Симптомы агалактии отсутствуют. Эти возбудители не вызывают воспалительной реакции влагалища. Выявление высокой концентрации возбудителя происходит случайно при плановом осмотре. У беременных признаки активации инфекции проявляются в виде уретрита или цистита.
Острый цистит сопровождается ухудшением общего состояния, слабостью, головной болью. Повышение температуры бывает редко.
Стрептококк агалактия при беременности выявляется у 20 % женщин. Отсутствие своевременного лечения может привести к развитию следующих осложнений:
- инфекция мочевыделительных путей;
- самопроизвольный аборт;
- послеродовый эндометрит;
- хориоамнионит;
- сепсис неонатального периода;
- пневмонию новорожденного;
- эндокардит;
- менингит.
Для женщины в большинстве случаев инфекция будет протекать скрыто, у новорожденного она часто является причиной осложнений.
Существуют определенные группы риска по развитию стрептококковой инфекции:
- преждевременные роды;
- длительный безводный промежуток более 18 часов;
- подъем температуры тела у женщины в родах;
- бактерии в моче;
- рождение недоношенного ребенка;
- маленький вес новорожденного;
- роды посредством кесарева сечения.
Если у женщины в предыдущих беременностях рождался ребенок со стрептококком агалакия, то обследование во вторых родах обязательно.
В плановом порядке беременным выполняют мазки из цервикального канала. Этот метод исследования позволяет определить степень чистоты влагалища и установить первые отклонения от нормы. Если в мазке преобладает кокковая флора, необходимо культуральное исследование, которое является основным методом диагностики инфекции.
https://youtube.com/watch?v=xm3PlRDlJdg
Для посева используют жидкие или плотные питательные среды. В некоторых лабораториях в них добавляют вещества, подавляющие рост других микроорганизмов. Это повышает выделение стрептококка на 50%.
Для посева материал берут из влагалища, аноректальной области. Рекомендуется брать отделяемое с нескольких участков слизистой одновременно. Это также увеличивает вероятность выявления возбудителя. Выявление 10 в 3 степени КОЕ/мл является вариантом нормы.
Поскольку роль стрептококка агалактия в инфицировании новорожденного очень велика, разработана система скрининг-тестов для выявления агалактии.
Для этого используют определение антигенов микроорганизма в латекс-агглютинации, ИФА, коагглютинации. Эти методы обладают высокой скоростью, но имеют некоторые недостатки.
Если проводить исследование в родах, то отделяемое из влагалища может быть смешано с околоплодными водами, кровью. Это понижает чувствительность тестов.
Также применяется ПЦР диагностика. С ее помощью можно выделять стрептококк агалактия в моче, отделяемом из влагалища, с кожи новорожденного. В ходе исследования определяется ДНК возбудителя. Последние разработки в этой области позволяют изучать гены вирулентности. Выявление такого генетического состава говорит о высокой вероятности инфицирования новорожденного тяжелой формой болезни.
Беременным исследование проводят на 35-37 неделе. Метод ПЦР позволяет выявить качественно и количественно стрептококк в исследуемом материале. Выявление количества микроорганизмов позволяет судить о зараженности исследуемого участка. Недостатком метода является то, что невозможно выявить живых представителей рода и определить их устойчивость к антибиотикам.
Статья по теме: Гинекологический мазок на флору
Как лечить стрептококк агалактию зависит от состояния женщины. Если она не планирует детей, нет симптомов заболевания, то достаточно провести небольшое местное лечение.
Для тех, кто планирует зачатие, лечение проводят только после появления симптомов.
Для беременной женщины, если определили стрептококк задолго до родов, но ярких симптомов нет, нужно наблюдать за ее состоянием, а в сроке 35 недель провести повторное исследование.
Инфекция может быть выделена и у кормящей матери. В таком случае назначают местное лечение до полного исчезновения признаков. Терапия антибиотиками для приема внутрь не проводится, т.к. они способны проникать в грудное молоко.
Рост и размножение бактерий подавляют следующие препараты:
- пенициллины;
- цефалоспорины;
- макролиды.
Это наиболее эффективное лечение. Препараты используют для приема внутрь.
Беременным даже при титре 10 в 6 степени на раннем сроке до 12 недель лечение не назначают. Это связано с особенностями формирования плаценты. После 12 недель можно проводить терапию с помощью препаратов для приема внутрь.
Важно при инфекции уретры и диагностированном цистите правильно подобрать беременной лечение – антибиотики некоторых групп запрещены для приема в связи с высоким риском перинатальной смерти.
Для местного лечения применяют вагинальные таблетки и свечи. Беременным необходима санация влагалища перед родами, чтобы уменьшить риск инфицирования новорожденного. Если санация не проводилась, но выявлен стерптококк 10 в 8 степени, то необходима антибактериальная терапия в родах.
Для местного использования применяют вагинальные таблетки Флуомизин. Они эффективны при бактериальном вагинозе. Также с его помощью можно проводить санацию влагалища пред родами и гинекологическими операциями.
К препарату практически не развивается устойчивость у микроорганизмов. Противопоказано применение препарата в возрасте до 18 лет, при аллергической реакции на один из его компонентов, язвенных изменениях слизистой влагалища.
Таблетку вводят глубоко во влагалище вечером перед сном. Курс лечения – 6 дней. При использовании лекарства менее этого срока, развивается устойчивость, в следующий раз эти же компоненты окажутся неэффективными.
Тержинан представляет собой желтоватую таблетку. В ее составе есть несколько действующих веществ, которые помогают бороться с бактериальной и грибковой инфекцией. Также в него входит преднизолон, который оказывает противовоспалительное действие, уменьшает отечность.
Тержинан можно применять у беременных со второго триместра, в период кормления грудью с большой осторожностью. Длительность терапии 10 дней. Таблетку перед использованием нужно смочить водой и поместить в положении лежа глубоко во влагалище. Если проводится лечение не у беременной женщины, то на время менструации прерывать терапию не нужно.
Стрептококком агалагкия заражаются не все новорожденные дети. Во многих случаях санация родовых путей или назначение антибиотика внутрь помогает снизить инфекционную нагрузку и вероятность заражения ребенка до 1-2%.
Streptococcus agalactiae в мазке у женщин не всегда указывает на воспалительный процесс. У 15–40% женщин детородного возраста встречается бактерионосительство, когда микроорганизм является элементом влагалищной микрофлоры и не причиняет беспокойства.
Но стрептококк агалактия относится к условно-патогенным микроорганизмам, поэтому при благоприятных условиях начинает размножаться, вызывая воспаление мочеполовой сферы.
Женщине следует знать, что это такое – стрептококковое носительство и как проявляется стрептококковая инфекция.
Streptococcus agalactiae в мазке у женщин – не всегда признак заболевания
- Количество streptococcus agalactiae в мазке у женщин, не превышающее 104 колонеобразующих единиц в миллилитре секрета, – вариант нормы, микроб безопасен для женского здоровья.
- Повышение содержания бактерий во влагалищной слизи указывает на развитие неспецифического воспаления, вызванного b-гемолитическим стрептококком группы В.
- Создают условия для активного размножения стрептококковых бактерий:
- снижение иммунитета;
- частые простудные инфекции;
- гормональные отклонения;
- эндокринные патологии;
- несоблюдение гигиены;
- самолечение антибиотиками;
- дисбактериоз кишечника или влагалища;
- прием гормонов или цитостатиков;
- стрессы;
- тесное белье, плохо пропускающее воздух;
- переохлаждения;
- незащищенный секс.
При беременности у носительниц streptococcus agalactiae размножение колоний происходит почти всегда.
Провоцируют активность микроорганизмов естественные изменения в организме, связанные с усилением секреции прогестерона и ослаблением иммунитета.
Патологическим отклонением, требующим лечения, считается показатель 105 и больше КОЕ/мл.
В большинстве случаев бактериальная инфекция не вызывает характерных симптомов. Несмотря на активное размножение условно-патогенной микрофлоры, женщина не испытывает дискомфорта.
Источник: https://14gkb.ru/streptococcus-agalactiae-streptokokk-agalaktiya-v-mazke-u-zhenschin-chto-eto-znachit-10-v-4-5-6-7-stepeni-lechenie/
Микрофлора влагалища представлена разнообразными микроорганизмами. В зависимости от их соотношения различают понятие нормы и патологии. Основу нормальной флоры составляют палочки – лактобактерии. Их дополняют условно-патогенные микроорганизмы, представленные стрептококками, стафилококками, гарднереллами, кандидами, уреа- и микоплазмами.
До тех пор, пока количество этих микроорганизмов незначительно, нет большого числа лейкоцитов, состояние влагалища считают удовлетворительным. Если в мазке из цервикального канала преобладает один из них, например, стрептококк агалактия, тогда диагностируют неспецифическое воспаление.
Поделиться: